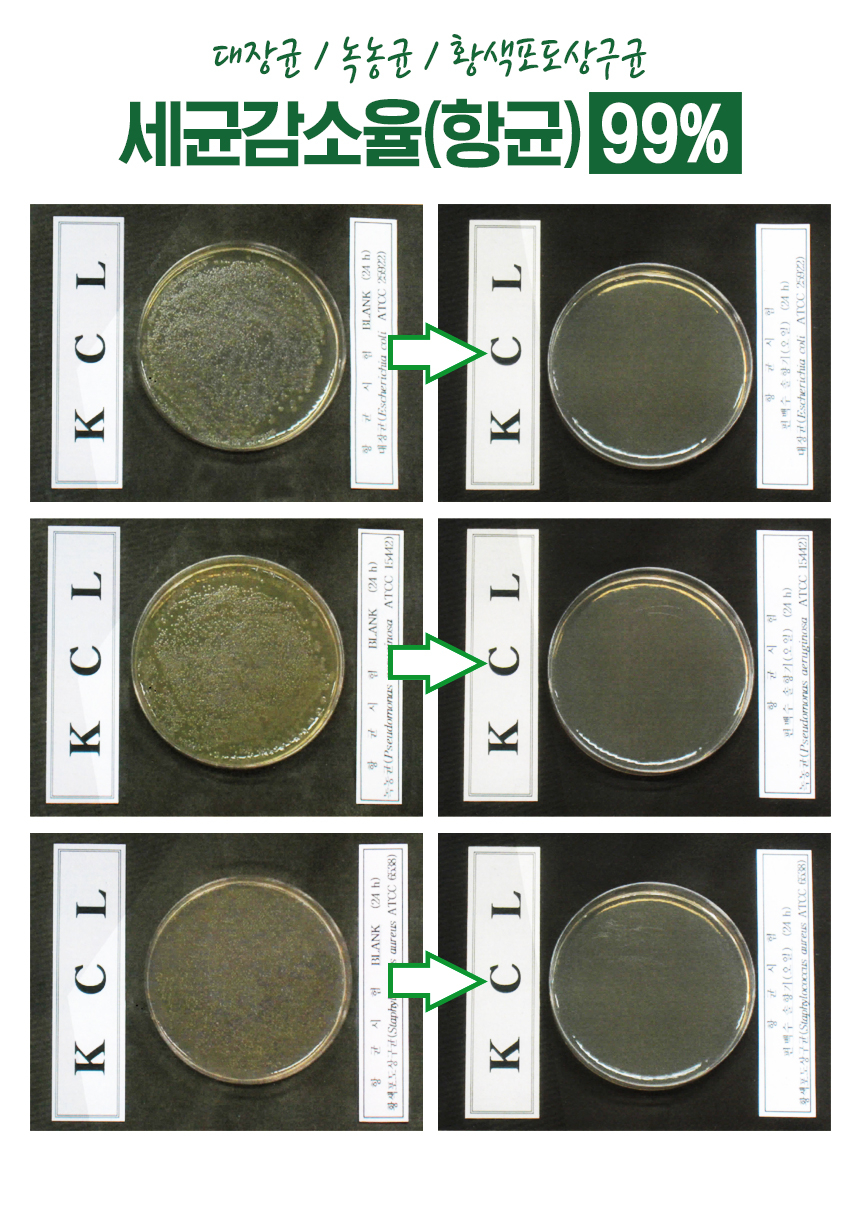

今日の為替レート
お振込銀行
クレジットカード支払い
ログイン | LOGIN
商品カテゴリー
- ブランドファッション
- ファッション/雑貨
- ビューティー
- 食品
- 出産/育児
- 生活雑貨
- パソコン
- レジャー
FDA등록 편백수 피톤치드 원액 라이노편백숲 2L
|
|||||||||||||||||
| 商品購入についてのご案内 | |||
|
|||

CE 인증 신청 중



COPYRIGHT ⓒ 2021 BY AFROM. ALL RIGHT RESEVED.










